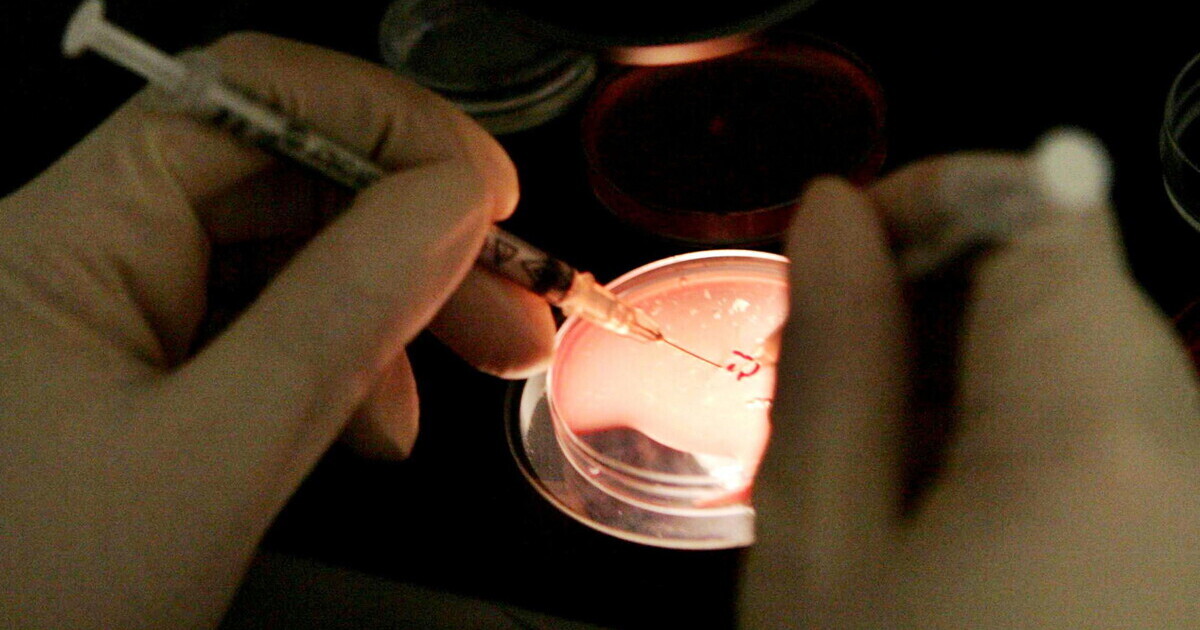

Se il welfare aziendale predica la crio-conservazione degli ovociti
Il welfare aziendale che promuove la crio-conservazione degli ovociti è al centro di un dibattito tra esperti e giuristi. Maurizio Del Conte, ex ministro del Lavoro e docente di Filosofia morale e Bioetica, esprime perplessità sulla sua applicazione e implicazioni etiche. La discussione riguarda sia i benefici per le lavoratrici sia le potenziali criticità di questa strategia nel contesto lavorativo e sociale.
Il giuslavorista laico Maurizio Del Conte, ex ministro del Lavoro, è perplesso. Il docente di Filosofia morale e Bioetica alla Cattolica, Alessio Musio, è decisamente contrario. E anche dai sindacati sono arrivati rilievi e critiche. Otb, Only the brave, è una multinazionale tascabile veneta dell’abbigliamento che fa capo a Renzo Rosso e i suoi marchi più famosi sono Diesel e Jil Sander. Ha una tradizione di welfare aziendale con un’attenzione spiccata alla diversità e all’inclusione. Ed è proprio l’ultima sua iniziativa in ordine di tempo a far discutere: un progetto di formazione sul tema della fertilità che comprende anche la crio-conservazione degli ovociti. 🔗 Leggi su Ilfoglio.it
© Ilfoglio.it - Se il welfare aziendale predica la crio-conservazione degli ovociti
Leggi anche: Il welfare aziendale è più inclusivo in Liguria, si allarga la platea dei beneficiari
Fiumicino aumenta i fondi per i dipendenti comunali e finanzia il welfare aziendaleFiumicino ha incrementato di 200 mila euro il Fondo del salario accessorio, in conformità con il “Decreto PA”.
Se il welfare aziendale predica la crio-conservazione degli ovociti - Negli ospedali pubblici italiani la pratica si può richiedere solo in presenza di gravi patologie, mentre nella sanità privata costa fino a 7 mila euro. ilfoglio.it
Le migliori organizzazioni per il welfare aziendale hanno scelto Scoop Travel come agenzia di riferimento per i viaggi dei propri dipendenti. Perché le vacanze sono una cosa seria: sono i momenti più belli della vita e vanno affidati a chi di viaggi se ne intende - facebook.com facebook
#Confartigianato #Treviso vi offre servizi completi per la gestione delle risorse umane in azienda: consulenza su contratti e normative del lavoro, elaborazione paghe, welfare aziendale, supporto in crisi aziendali e contenziosi e molto altro. Scoprite di più x.com
È possibile cercare altre notizie e contenuti video collegati allo stesso argomento trattato.